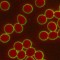
一滴血檢測儀相機 一滴血檢測儀相機
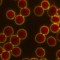
一滴血檢測儀相機 一滴血檢測儀相機

一滴血檢測儀相機
XGA解析度,30fps,無拖尾
黑背景,80萬圖元高速拍攝
高保真的色彩還原
SGJPLY一滴血檢測儀相機,主要應用在顯微鏡上面。具有同時具有黑背景、亮背景雙重功能(黑背景、亮背景自由轉換;同時可看活血和幹血,能在電腦即時預覽與拍攝放大圖像,操作簡單、快捷,廣泛應用在醫院、診所及健康中心的理想拍攝儀器。
- 1.SGJPLY超顯微技術黑背景一滴血檢測儀相機背景可以設定為黑色,細胞立體感更強 ,
- 2.能清晰觀察到甘油三脂、乳靡微粒、血小板針狀體、寄生蟲、白細胞分葉等血液中半透明成份;
- 3.能清晰看見白細胞形態、並能清晰看到白細胞吞噬血液中的微生物過程,從而可以推斷免疫力大小。
一滴血檢測儀相機不靠生化手段推測病原體、對病原體直接觀察、無需染色培養、方便簡單、診斷快速, 無限遠顯微光學系統下實現一滴血檢測、亞健康檢測。能進行以下檢查:
1、人體健康評估
通過檢測人體血液紅細胞、血小板數目、白細胞數目、組織的完整性分析瞭解到人體的一般病理、病毒、細菌感染、血脂、血清變化、癌症、寄生蟲、免疫系統、營養狀況等。通過HLB血液分析,瞭解癌症不同階段,免疫系統狀況、內分泌激素,維生素B、C,心臟功能關態,及過敏反應等。
2、精液檢查
估計精子數量、活動力、成活率、精子有無畸形及死精、精子病原體感染。
3、前列腺液檢查
外觀顏色、卵磷脂小體、紅細胞、白細胞、結晶體狀態、前列腺液的病原體感染、卵磷脂小體的病原體感染。
4、陰道分泌物檢查
清潔度、上皮細胞、正常菌群、白細胞、膿細胞、線索細胞、宮頸癌細胞滴蟲、念珠菌等性病病原體。
5、脫落積液檢查
心包液、胸腹水、腦脊液、關節腔積液等中的脫落細胞的常規檢測、各種積液中的病原體感染的檢查。
6、尿液檢查
結晶、管型、紅細胞、白細胞、膿細胞、細菌。
7、性病病原體檢查
淋病雙球菌、滴蟲、梅毒螺旋體、念珠菌、加德納菌、杜克雷嗜血桿菌、弓形蟲、沙眼衣原體、解脲支原體。
8、微生物、細菌和水質分析
|
相機 |
一滴血檢測儀相機 |
| 型號 | SG-G1UC080C |
| 感測器類型 | 1/3英寸 彩色 SONY CCD |
| 解析度 | 1024 x 768 |
| 圖元點尺寸 | 2.2μm x2.2μm |
| 靈敏度 | 0.4V |
| 掃描方式 | 逐行 |
| 幀率 | 30fps@ 1024 x 768 |
| 數位格式 | 10 bit |
| 信噪比 | 44 dB |
| 曝光時間 | 35μs–66ms,自動曝光 |
| 白平衡 | 一鍵白平衡/區域白平衡 |
| 光譜回應 | <500mA |
| 資料介面 | USB2.0速度480Mb/s 線纜長度3M |
| 鏡頭介面 | C介面 |
| 工作溫度 | 0°C ~ 60°C |
| 工作濕度 | 0-85% |